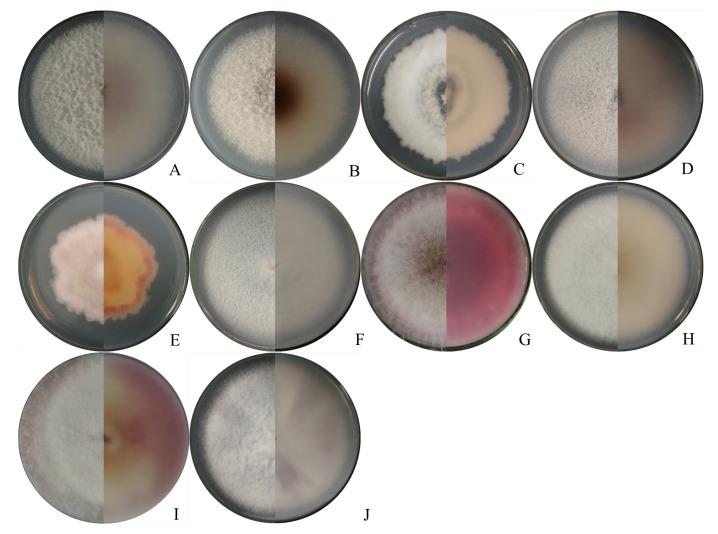
https://cdn.ncbi.nlm.nih.gov/pmc/blobs/dee2/9501324/fe28928416d4/ijms-23-10821-g002.jpg

中国黑龙江省玉米鞘腐病相关 spp. 的鉴定、致病性和遗传多样性。
Identification, Pathogenicity, and Genetic Diversity of spp. Associated with Maize Sheath Rot in Heilongjiang Province, China.
机构信息
Key Laboratory of Agricultural Microbiology of Heilongjiang Province, School of Life Sciences, Northeast Agricultural University, No. 600 Changjiang Road, Harbin 150030, China.
State Key Laboratory for Biology of Plant Diseases and Insect Pests, Institute of Plant Protection, Chinese Academy of Agricultural Sciences, Beijing 100097, China.
出版信息
Int J Mol Sci. 2022 Sep 16;23(18):10821. doi: 10.3390/ijms231810821.
Maize sheath rot is a prevalent maize disease in China. From 2020 to 2021, symptomatic samples were collected from the main maize-growing regions of Heilongjiang province. To clarify the population and genetic diversity, as well as the virulence of pathogens responsible for maize sheath rot, a total of 132 isolates were obtained and used for follow-up studies. Ten species were identified based on morphological characteristics, and phylogenetic analysis was conducted using the TEF-1α gene sequences, including (50.00%), (18.94%), the species complex (14.39%), (5.30%), (3.03%), (2.27%), (2.27%), (1.52%), (1.52%), and (0.76%). All 10 species could produce oval-to-annular lesions on maize sheath, and the lesions were grayish yellow to dark brown in the center and surrounded by a dark gray-to-dark brown halo. Of these, and showed significantly higher virulence than the other species. In addition, haplotype analysis based on the concatenated sequences of the ITS and TEF-1a genes showed that 99 isolates which belonged to the species complex-consisting of isolates, isolates, isolates, and isolates-could be grouped into 10 haplotypes, including 5 shared haplotypes (Haps 1, 2, 4, 5, and 6) and 5 private haplotypes (Haps 3, 7, 8, 9, and 10). Furthermore, the clade in the haplotype network was radial with the center of Hap 2, suggesting that population expansion occurred. This research showed that species associated with maize sheath rot in Heilongjiang province are more diverse than previously reported, and this is the first time that , , , , , and have been confirmed as the causal agents of maize sheath rot in Heilongjiang province.
玉米叶鞘腐烂病是中国普遍发生的一种玉米病害。2020 年至 2021 年,从黑龙江省主要玉米种植区采集了有症状的样本。为了阐明引起玉米叶鞘腐烂病的病原菌的种群和遗传多样性以及毒力,共获得了 132 个分离物用于后续研究。根据形态特征鉴定了 10 个种,并用 TEF-1α 基因序列进行了系统发育分析,包括 (50.00%)、 (18.94%)、 种复合体(14.39%)、 (5.30%)、 (3.03%)、 (2.27%)、 (2.27%)、 (1.52%)、 (1.52%)和 (0.76%)。所有 10 个种都能在玉米叶鞘上产生椭圆形到环形的病斑,病斑中心呈灰黄色至深褐色,周围有深灰色至深褐色晕圈。其中, 和 表现出比其他种更高的毒力。此外,基于 ITS 和 TEF-1a 基因的串联序列的单倍型分析表明,属于 种复合体的 99 个分离物——包括 个分离物、 个分离物、 个分离物和 个分离物——可以分为 10 个单倍型,包括 5 个共享单倍型(单倍型 1、2、4、5 和 6)和 5 个私有单倍型(单倍型 3、7、8、9 和 10)。此外,单倍型网络中的 分支呈放射状,以单倍型 2 为中心,表明发生了种群扩张。本研究表明,黑龙江省与玉米叶鞘腐烂病有关的 种比以前报道的更为多样化,这是首次确认 、 、 、 、 和 为黑龙江省玉米叶鞘腐烂病的病原菌。